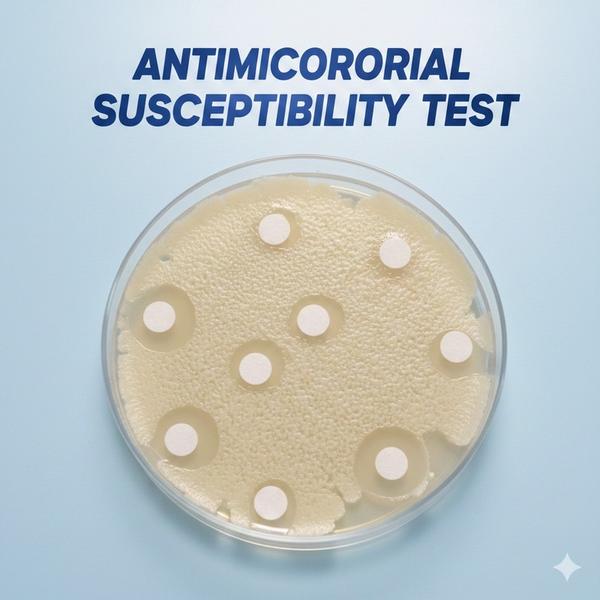
product image
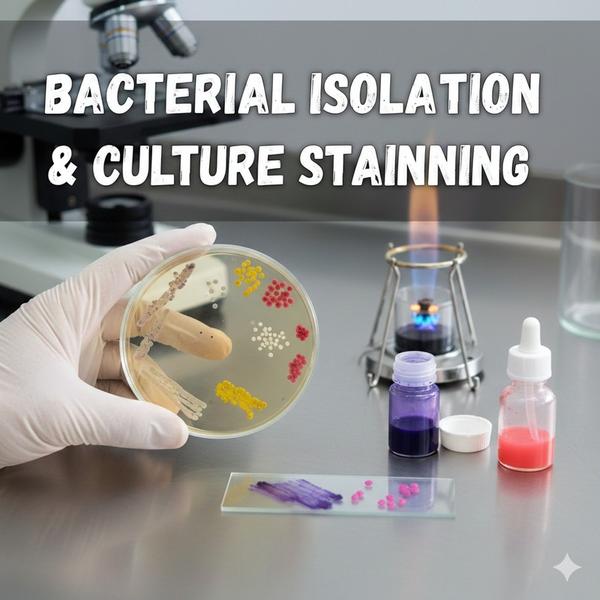
product image

At Dextrose Technologies Pvt. Ltd., we support biofilm studies to help researchers and product teams evaluate how microbes form biofilms and how effectively treatments prevent, reduce, or eradicate them. Since biofilm workflows vary widely by organism, surface, and endpoint, these services are offered capability- and scope-dependent, with study design finalized based on your objective and sample constraints. Biofilm Formation Assays We assess the ability of bacterial or fungal isolates to form biofilms under defined conditions, generating comparable outputs across strains, media, or surfaces. Biofilm Inhibition Studies We evaluate treatments and formulations for their ability to prevent or reduce biofilm formation when applied at defined concentrations and timepoints. Biofilm Eradication / Reduction Studies We assess the impact of treatments on pre-formed biofilms, generating reduction trends to support comparative performance evaluation. Deliverables * Agreed test plan (organism, surface, conditions, timepoints) * Quantified results and comparative summary (endpoint as per scope) * Interpretation notes aligned to your decision goal (screening vs benchmarking) * Optional: follow-up plating/viability confirmation where required Get started Share the organism, surface type (plastic/steel/glass/other), test agents/formulation, and endpoint you want (screening, reduction %, viability). We’ll confirm feasibility and propose the most reliable workflow.